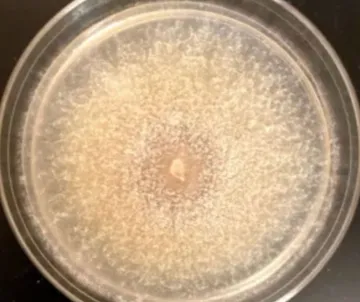
raffaelea montetyi

Although Sudden Oak Death from Phytophthora ramorum infection is currently more prevalent in Northern California, its iconic oak woodlands are facing yet another serious threat: Xyleborus mediterraneus, also known as the Mediterranean Oak Borer (MOB). The Mediterranean Oak Borer, an ambrosia beetle, poses a substantial risk to the oak ecosystems of the Loma Prieta Chapter, and local foresters, ecologists, and governments are raising the alarm about it.

MOB targets white oak species (Quercus alba), especially valley oak (Quercus lobata), as well as blue oak (Q. douglasii). In some areas, black oaks (Quercus kelloggii) have also been affected. It primarily attacks trees that are stressed by heat, drought, age, or other environmental pressures.
The beetles fly and travel on firewood or yard trimmings. It is challenging to detect them because they are so small. Adult females measure about 3 millimeters long, roughly 1/10th of an inch, comparable to the size of a sesame seed or a piece of pencil “lead”. Males are even smaller and rarely seen.
MOB beetles originated in Europe, the Levant, and North Africa, specifically in the regions surrounding the Mediterranean Sea, where they are native to the oaks. In their native habitat, they fulfill a valuable ecological role by being attracted to trees that are already destined to die. They help decompose the trees and ultimately return their nutrients to the soil. Their lifecycle ends after a single generation, and the next generation moves on to another dying tree. The beetle functions more as a secondary pest, contributing to the decay of already compromised trees. As such, MOB is considered a minor pest with limited ecological disruption due to the presence of natural predators and balanced forest dynamics.
In the U.S, MOB functions as an invasive species; it is more aggressive, infesting live, seemingly healthy trees and causing significant damage. Females tunnel into stressed oaks that are otherwise likely to survive. They breed for multiple generations, ultimately killing any tree they infest. Spread of the beetles is facilitated by both natural dispersal (flying females) and human activities, especially the movement of infested wood. In invaded areas of the U.S., there are currently no known effective natural predators or biological control agents specifically targeting it.
Like many wood-boring pests, MOB likely arrived in the U.S. via international trade. DNA analyses show that the California population traces back to France. A separate population in Oregon originated in Germany and is found primarily in the Willamette Valley, where its primary host tree is the Oregon oak (Q. garryana).
The California population of the beetle was initially detected in Napa Valley and has since spread rapidly throughout Northern California. Specimens collected in 2017, two years before it was first confirmed, indicate it may have been present as far back as 2012, and possibly even earlier.
Unlike typical wood-boring beetles, MOB doesn’t feed on the wood itself. Females bore into trunks and branches and lay eggs in tunnels called “galleries” (incidentally, the only place males can be found). The beetles carry a cultivated symbiotic fungus, Raffaelea montetyi. It serves as food for both adult beetles and their larvae. The problem is that fungus spreads through the tree’s tissues, disrupting its ability to move water and nutrients. Over time, this fungal invasion, combined with damage from tunneling, can weaken and eventually kill the tree. Unlike in its native habitat, the beetle can produce multiple generations per year, accelerating tree decline.

Red flags for a possible tree infestation include dead or dying branches, particularly in the upper canopy with sparse foliage. There may even be just a single branch affected initially, while the rest of the tree looks healthy. Clusters of tiny, round entry holes, about the size of a pinhead, can be seen on the trunk or branches, along with fine boring dust called frass around the entry holes or at the base of the tree. Another telltale sign of MOB infestation is wet staining or moisture seepage, where sap and moisture may seep, creating dark, wet-looking patches on the bark.

In already cut wood, MOB-infested branches or trunks, exhibit galleries that appear as tightly packed, fan-like or trellis-shaped tunnels, unlike the rounder or more scattered galleries left by native beetles.
In areas with MOB infestations, increased woodpecker activity has been observed around affected trees. This suggests they may be targeting MOB larvae inside the wood. They do consume beetle larvae, although they’re more like opportunistic feeders than dedicated MOB hunters. Their impact is insufficient to stop infestations.
Within the Loma Prieta Chapter (San Mateo, Santa Clara, and San Benito Counties), Santa Clara County confirmed MOB infestations in 2021. While it has yet to release a specific action plan for MOB, the County is increasing efforts to assess the spread of MOB and educate the public on identifying affected trees through its broader Invasive Pest Management Program. The City of San José partnered with UC Agriculture and Natural Resources to host a free webinar on the Mediterranean Oak Borer (MOB) and other oak pests in April of this year. The event was part of a broader effort to raise awareness about invasive ambrosia beetles threatening California’s oak trees.
MOB has not yet been formally detected in San Benito or San Mateo Counties, but both are at high risk due to their proximity to infested areas, and as yet, these counties have not released an official response plan; however, the broader regional approach across Northern California offers insight into what their agriculture officials may be doing or preparing to do. Regional response strategies include active monitoring and early detection, public education, collaboration with forestry experts, and containment measures.
Controlling MOB is challenging due to its cryptic lifestyle and ability to spread easily. Forestry experts warn that the beetle can easily spread via firewood or untreated wood products. Local landowners are being encouraged to report suspicious tree damage and avoid transporting wood across county lines. Firewood transported over distances no greater than 20 miles minimizes the risk of spread, as does aging it for at least two years, since beetles can, under the right conditions, remain in the wood material for that long. Another strategy recommended by experts includes chipping infested timber. Reducing wood to chips smaller than one inch can kill the beetle. Composting at high temperatures (above 160°F) is also effective. Currently, there are no proven chemical treatments available to control MOB.
In already cut wood, signs of MOB include entry holes, frass in cracks and crevices around holes, tunnel-like galleries, dark staining or streaks, and, in an advanced infestation, a soft or crumbly texture.
The best way for individual landowners to protect their oaks is to keep them healthy and well-maintained. Mulch placed around trunks can preserve moisture and reduce root stress, and deep watering of trees during dry spells is especially beneficial for young or vulnerable trees. Pruning oaks during the winter is beneficial for removing dead, diseased, or damaged branches, improving air circulation and sunlight penetration, and shaping the tree for structural integrity. Avoid injuring tree trunks with tools.
One of the most important things to do is stay vigilant. Trees should be regularly inspected, especially in late spring and early summer, when beetle activity is at its highest. If a tree exhibits the signs of possible MOB, as discussed above, an arborist should be consulted.
Research on MOB is underway, but it is in its infancy because of the beetle's relatively recent arrival in California. The UC Agriculture and Natural Resources (UC ANR) and the UC Statewide IPM Program are actively studying MOB’s biology, behavior, and impact on native oaks. Their goal is to develop monitoring tools and management guidelines. The Clear Lake Environmental Research Center (CLERC) is conducting a MOB Monitoring Project to track the spread of the organism and assess tree health in affected areas. This helps identify patterns and potential intervention points. Other researchers at CLERC are investigating the role of the fungus Raffaelea montetyi, which is responsible for infecting the trees that carry the MOB. Understanding the symbiosis between the borer and the fungus may be key to developing biological or chemical controls.
California’s oak ecosystems are treasured for their beauty, and they are vital for biodiversity, carbon storage, and cultural heritage. Coordinated efforts between counties, researchers, and the public are essential to slow the spread of the Mediterranean Oak Borer and protect those that are most vulnerable.
Residents should report suspected infestations through UC Agriculture’s online portals to aid in early detection. To report an infestation, visit UC IPM’s MOB resource page.
Resources:
Forest Protection Forums | Stop Clearcutting CA | Matt Banchero
Invasive Species – Mediterranean Oak Borer
Mediterranean Oak Borers and Other Pests of California Oaks
Mediterranean Oak Borer: Questions & Answers
What You Can Do About the Mediterranean Oak Borer
Inspection Checklist for Mediterranean Wood Borer - Google Docs